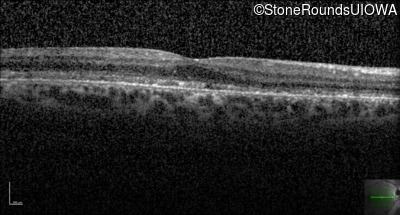
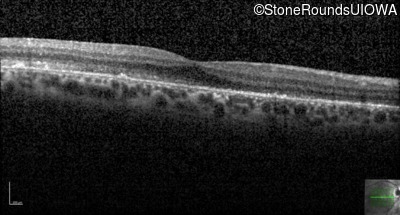
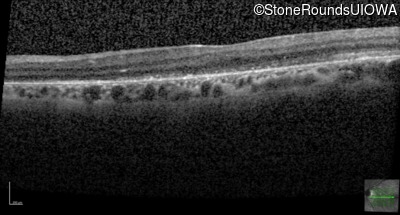
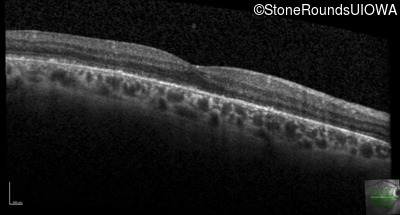
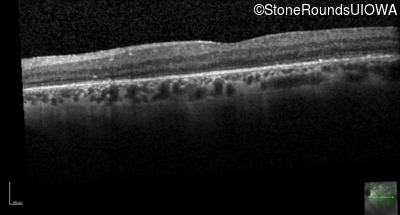
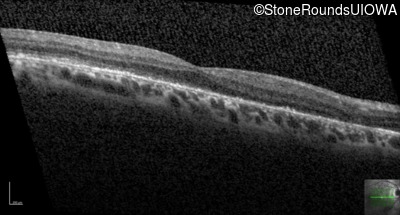
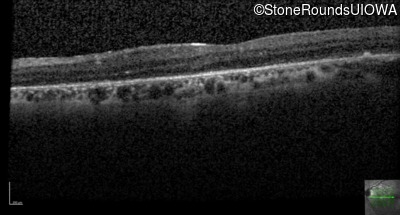
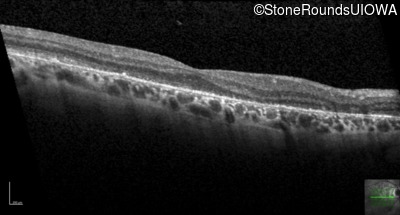
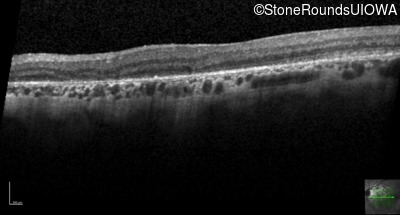
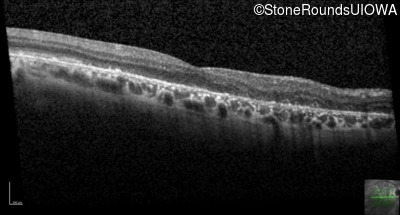
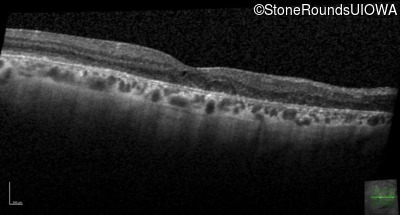
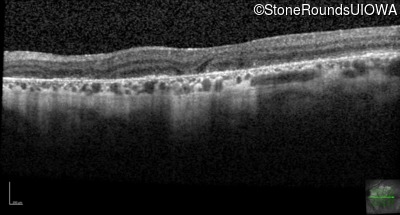
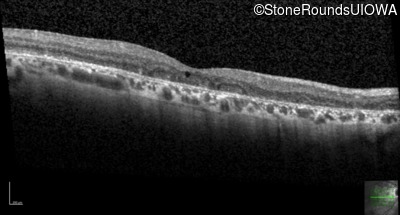
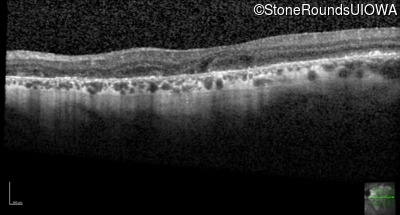
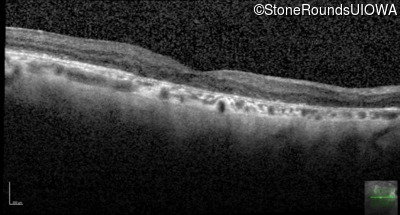
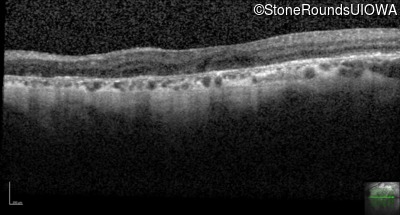
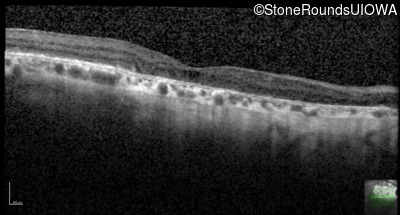
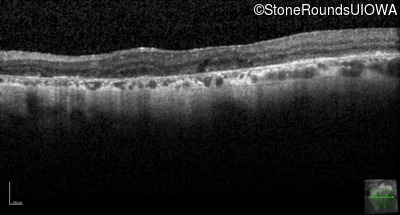
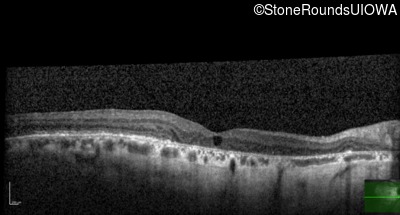
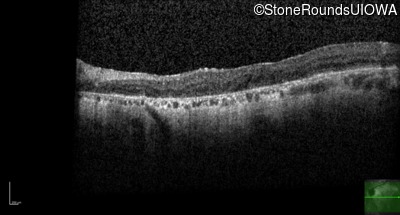
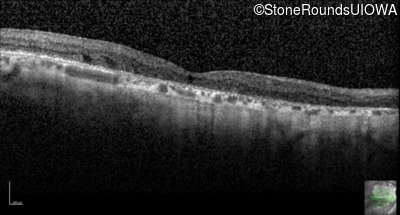
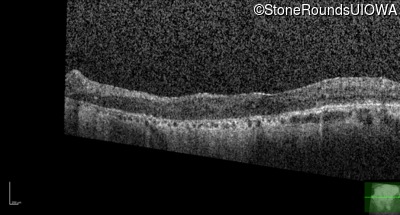
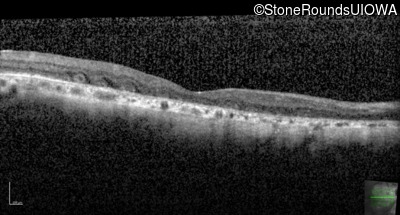
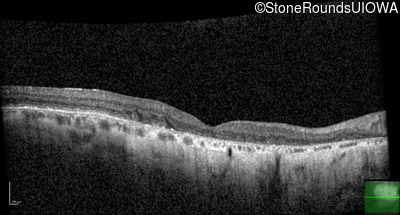
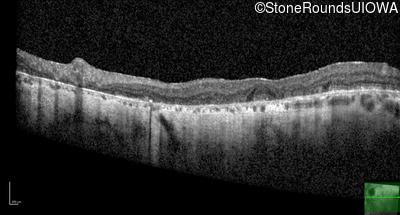
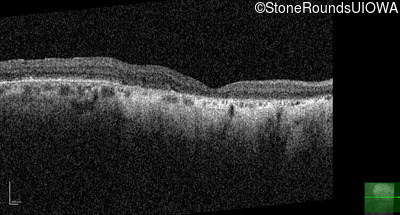
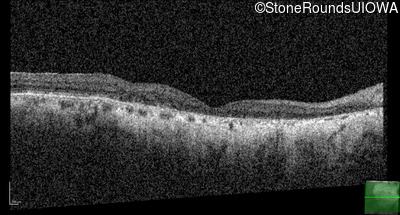
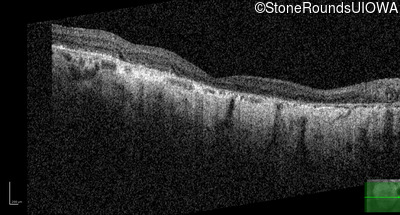

Case
SR337
Student Mode
Foveal Hypoplasia (IIIG)
Female
Female
Hidden
SR337
Student Mode
Foveal Hypoplasia (IIIG)
Female
Female
| Age at visit: 55 years |
| Age at visit: 57 years (Visit 2) |
| Age at visit: 58 years (Visit 2) |
| Age at visit: 59 years (Visit 2) |
| Age at visit: 60 years (Visit 2) |
| Age at visit: 62 years |
| Age at visit: 63 years (Visit 2) |
Diagnosis & molecular findings
| Disease | Gene | Allele 1 variant(s) | Allele 2 variant(s) | Inheritance mode |
|---|---|---|---|---|
| Foveal Hypoplasia | PAX6 | Pro76Leu CCG>CTG | AD |